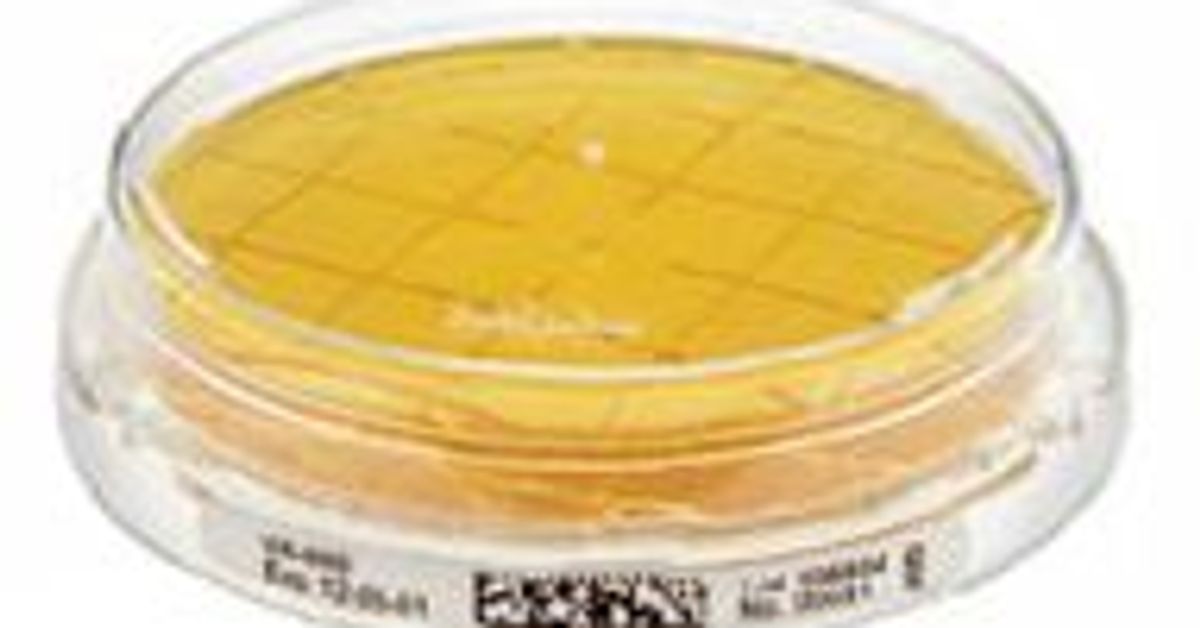

Emd Millipore Catalog 40-285 Or Equivalent
Emd Millipore Catalog 40-285 Or Equivalent - Analyzing this sample raises profound questions about choice, discovery, and manipulation. Once you are ready to drive, starting your vehicle is simple. I used to believe that an idea had to be fully formed in my head before I could start making anything. In this context, the value chart is a tool of pure perception, a disciplined method for seeing the world as it truly appears to the eye and translating that perception into a compelling and believable image. As artists navigate the blank page, they are confronted with endless possibilities and opportunities for growth. The great transformation was this: the online catalog was not a book, it was a database. Its complexity is a living record of its history, a tapestry of Roman, Anglo-Saxon, and Norman influences that was carried across the globe by the reach of an empire. You are not bound by the layout of a store-bought planner. It shows us what has been tried, what has worked, and what has failed. The design philosophy behind an effective printable template is centered on the end-user and the final, physical artifact. So, we are left to live with the price, the simple number in the familiar catalog. This multimedia approach was a concerted effort to bridge the sensory gap, to use pixels and light to simulate the experience of physical interaction as closely as possible. It offers advice, tips, and encouragement. The online catalog, in becoming a social space, had imported all the complexities of human social dynamics: community, trust, collaboration, but also deception, manipulation, and tribalism. The first online catalogs, by contrast, were clumsy and insubstantial. If you wish to grow your own seeds, simply place them into the small indentation at the top of a fresh smart-soil pod. The act of looking at a price in a catalog can no longer be a passive act of acceptance. They were pages from the paper ghost, digitized and pinned to a screen. His concept of "sparklines"—small, intense, word-sized graphics that can be embedded directly into a line of text—was a mind-bending idea that challenged the very notion of a chart as a large, separate illustration. 26 For both children and adults, being able to accurately identify and name an emotion is the critical first step toward managing it effectively. The primary material for a growing number of designers is no longer wood, metal, or paper, but pixels and code. " The Aura Grow app will provide you with timely tips and guidance on when and how to prune your plants, which can encourage fuller growth and increase your harvest of herbs and vegetables. The journey through an IKEA catalog sample is a journey through a dream home, a series of "aha!" moments where you see a clever solution and think, "I could do that in my place. Looking back at that terrified first-year student staring at a blank page, I wish I could tell him that it’s not about magic. The layout is a marvel of information design, a testament to the power of a rigid grid and a ruthlessly consistent typographic hierarchy to bring order to an incredible amount of complexity. " "Do not add a drop shadow. The social media graphics were a riot of neon colors and bubbly illustrations. The utility of such a simple printable cannot be underestimated in coordinating busy lives. The template is a servant to the message, not the other way around. It connects a series of data points over a continuous interval, its peaks and valleys vividly depicting growth, decline, and volatility. Carefully align the top edge of the screen assembly with the rear casing and reconnect the three ribbon cables to the main logic board, pressing them firmly into their sockets. The core concept remains the same: a digital file delivered instantly. Beginners often start with simple projects such as scarves or dishcloths, which allow them to practice basic stitches and techniques. A personal development chart makes these goals concrete and measurable. The Bauhaus school in Germany, perhaps the single most influential design institution in history, sought to reunify art, craft, and industry. The digital tool is simply executing an algorithm based on the same fixed mathematical constants—that there are exactly 2. They can walk around it, check its dimensions, and see how its color complements their walls. But I now understand that they are the outcome of a well-executed process, not the starting point. He was the first to systematically use a line on a Cartesian grid to show economic data over time, allowing a reader to see the narrative of a nation's imports and exports at a single glance. An incredible 90% of all information transmitted to the brain is visual, and it is processed up to 60,000 times faster than text. Our consumer culture, once shaped by these shared artifacts, has become atomized and fragmented into millions of individual bubbles. Master practitioners of this, like the graphics desks at major news organizations, can weave a series of charts together to build a complex and compelling argument about a social or economic issue. Instead, it is shown in fully realized, fully accessorized room settings—the "environmental shot. This resilience, this ability to hold ideas loosely and to see the entire process as a journey of refinement rather than a single moment of genius, is what separates the amateur from the professional. I thought professional design was about the final aesthetic polish, but I'm learning that it’s really about the rigorous, and often invisible, process that comes before. There are even specialized charts like a babysitter information chart, which provides a single, organized sheet with all the essential contact numbers and instructions needed in an emergency. It’s a funny thing, the concept of a "design idea. This act of visual translation is so fundamental to modern thought that we often take it for granted, encountering charts in every facet of our lives, from the morning news report on economic trends to the medical pamphlet illustrating health risks, from the project plan on an office wall to the historical atlas mapping the rise and fall of empires. You do not need the most expensive digital model; a simple click-type torque wrench will serve you perfectly well. The goal is to provide power and flexibility without overwhelming the user with too many choices. And, crucially, there is the cost of the human labor involved at every single stage. The instructions for using the template must be clear and concise, sometimes included directly within the template itself or in a separate accompanying guide. In our digital age, the physical act of putting pen to paper has become less common, yet it engages our brains in a profoundly different and more robust way than typing. From a young age, children engage in drawing as a means of self-expression and exploration, honing their fine motor skills and spatial awareness in the process. Faced with this overwhelming and often depressing landscape of hidden costs, there is a growing movement towards transparency and conscious consumerism, an attempt to create fragments of a real-world cost catalog. The faint, sweet smell of the aging paper and ink is a form of time travel. A designer who only looks at other design work is doomed to create in an echo chamber, endlessly recycling the same tired trends. This simple grid of equivalencies is a testament to a history of disparate development and a modern necessity for seamless integration. I had to create specific rules for the size, weight, and color of an H1 headline, an H2, an H3, body paragraphs, block quotes, and captions. These digital files are still designed and sold like traditional printables. Your new Ford Voyager is equipped with Ford Co-Pilot360, a comprehensive suite of advanced driver-assist technologies that work together to provide you with greater confidence and peace of mind on the road. Abstract goals like "be more productive" or "live a healthier lifestyle" can feel overwhelming and difficult to track. 50 Chart junk includes elements like 3D effects, heavy gridlines, unnecessary backgrounds, and ornate frames that clutter the visual field and distract the viewer from the core message of the data. Beauty, clarity, and delight are powerful tools that can make a solution more effective and more human. The rhythmic motion of the needles and the repetitive patterns can induce a state of relaxation and mindfulness, providing a welcome escape from the stresses of modern life. It is in this vast spectrum of choice and consequence that the discipline finds its depth and its power. By respecting these fundamental safety protocols, you mitigate the risk of personal injury and prevent unintentional damage to the device. The archetypal form of the comparison chart, and arguably its most potent, is the simple matrix or table. If for some reason the search does not yield a result, double-check that you have entered the model number correctly. A template immediately vanquishes this barrier. 22 This shared visual reference provided by the chart facilitates collaborative problem-solving, allowing teams to pinpoint areas of inefficiency and collectively design a more streamlined future-state process. A scientist could listen to the rhythm of a dataset to detect anomalies, or a blind person could feel the shape of a statistical distribution. Having to design a beautiful and functional website for a small non-profit with almost no budget forces you to be clever, to prioritize features ruthlessly, and to come up with solutions you would never have considered if you had unlimited resources. It might be their way of saying "This doesn't feel like it represents the energy of our brand," which is a much more useful piece of strategic feedback. If necessary, it may also provide a gentle corrective steering input to help you get back into your lane. It starts with low-fidelity sketches on paper, not with pixel-perfect mockups in software. This is where the ego has to take a backseat. They are integral to the function itself, shaping our behavior, our emotions, and our understanding of the object or space.EMD Millipore PIDC Construction
EMD Millipore 1.19898.0500 Certipur Phosphate Standard Solution
EMD Millipore Launches VegetableBased Contact Agar for Isolator and
MilliporeSigma Microbial Monitoring Tools Gusmer Beer
EMD Millipore 1.10283.0500 LB Agar Miller, Granulated, 500g Poly Bottle
EMD Millipore MFMillipore HAWP09000 Mixed Cellulose Ester Filter
MilliporeSigma Microbial Monitoring Tools Gusmer Beer
EMD Millipore MPGP04001, Millipak® 40 Express Final Filter, 0.22 Micron
EMD Millipore MC0HC10FS1 Millipore Millistak+® HC Pod Depth Filter
EMD Millipore MPGL04GK2, Millipak® 40 Final Filter, 2/pkg ServAPure
Bisulfite Conversion Kit EMD Millipore
EMD Millipore Products General Laboratory Supply
EMD MILLIPORE KVGLA04HH3 Opticap XL4 Polypropylene NonSterile Durapore
Emd Millipore Mcolorphast 1.09543.0001 NonBleeding PhIndicator Strip
EMD Millipore 1.08409.0100 Ethylendiamintetraacetic Acid Magnesium
EMD Millipore 1.06586.0500 EMSURE DiSodium Hydrogen Phosphate
MilliporeSigma™ Millipak™ Disposable Filter Units Fisher Scientific
EMD Millipore Expands EZProduct Family for Faster, More Efficient
MilliporeSigma Filter Cartridges Gusmer Enterprises
EMD Millipore 1.00804.0250 L(+)Tartaric Acid for Analysis EMSURE ACS
EMD Millipore 1.01960.0001 Certipur Potassium Dihydrogen Phosphate, Di
Microbiological air sampler EMD Millipore MAS100 (Free shipping in
EMD Millipore 1.120SB.0101 Readycult Sample Bottle, Sterile, 120mL
EMD Millipore MPGL04001 Millipak40 Filter Unit, 0.22 µm Pore Size, Non
Fractogel® EMD TMAE (M) 116881
EMD Millipore Sistema de purificación de agua pura RiOs 3
List of Manufacturers PCI SCIENTIFIC SUPPLY, INC.
EMD Millipore MPGP04001 Millipak Express 40 Filter Unit, 0.22µm Size
EMD Millipore 1.00607.0001 Spectroquant Ozone Test Method
EMD Millipore 1.25045.0100 N itrate Standard Solution, CRM traceable to
EMD Millipore HVLP04700 Durapore Membrane, PVDF, 0.45 µm, 47 mm dia
EMD MILLIPORE 3P BIOPHARM Disposable Diverter Plate, 10/pk, Quantity
Microbiological Air Sampler EMD Millipore MBV MAS used with warranty
EMD Millipore 1.02051.9025 Chemizorb Powder Absorbent for Spilled
Related Post: